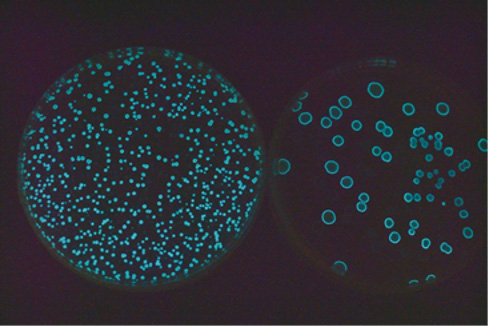

Taiwan Farm Expo showcases over 250 exhibitors already booked and more to come as the biggest agriculture livestock and aquaculture technologies

It’s time to pack your bags for the interesting Asia Agri-Tech Expo and Forum. It will take place this year on 10 to 12 of November 2022 at the Taipei Nangang Exhibition Center in Taiwan.
This expo is a little different as it is combining with the Livestock and Aquaculture Taiwan Expo and Forums, as well as Cold Chain and Meat Taiwan to make this year a four-into-one exhibition.
Already booked are 250 exhibitors from 15 countries, who will bring to visitors the whole “Farm to Market” value chain of products, technologies, solutions, and services.
It is anticipated over 18,000 buyers and professional visitors from 30 countries will attend the 2022 Expo.
The Council of Agriculture, Executive Yuan of Taiwan (COA) will present 23 Taiwanese agricultural companies in a special exhibition to be called the Taiwan Agricultural Technology Pavilion at the Taipei Nangang Exhibition Centre, Hall 1.
These 23 Taiwanese agricultural companies will showcase a total of 60 agriculture, livestock, and aquaculture technologies, products, and services, including seeds, seedlings, bio-fertiliser, bio-pesticide, Breeding of aquatic fries, pig breeding, and layer’s animal welfare production model.
it’s the 6th year the Taiwan Agricultural Technology Pavilion will be staged and there are many cutting edged agriculture, livestock, aquaculture technologies that will be showcased at the Expo this year.
Taiwanese is very interested in developing agricultural technologies and making them available to world markets.
Here is a selection of some of the products released especially for the Taiwan Agricultural Expo.

Tomato3706 and other seedlings
Your Chain Seed Co., Ltd. will showcase Tomato3706 seedlings, that are semi-determinate, early maturing varieties, and resistant to heat up to 38℃, but with 8°Bx+.
This variety has a long vine life, is firm and suitable for long term storage and long-distance transportation.
Besides tomato seedlings, Your Chain will display Powdery Mildew Race 1 melon, and luffa that can retain the same fresh colour after cooking.
Pest free controlled plants
Sinon Corporation will exhibit Photorhabdus Luminescents (PL)-P2R for the first time, a technology developed by the Taiwan based Toxic Substances Research Institute, Council of Agriculture.
Photorhabdus Liminescents (PL)-P2R is the world’s first microbial miticide, that is intended to limit pest attacks with a protein-based substance. There is said to be no pesticide residues and no harm to more beneficial insects.
This is the first technology in agriculture to use ELISA as quality control.

Unique Pinpu black pigs
The Taiwanese local pig species called Pinpu black pigs that has been successfully developed by Pin-pu Farm Corp will be on show.
Pin-pu Farm Corp performed DNA testing and developed eugenics to create this Taiwanese local pig species, Pinpu black pigs.
It is said the taste of Pinpu Black Pig pork is smooth, springy, tender, juicy, sweet, and refreshing. What more could you ask for.
The first to import into Australia will make a fortune.
In addition to the companies mention, on display will also be some of Taiwann and the world’s most forward thing companies, such as Huang Lin Machinery Co, FongYu Corp, It’s Science Corporation, Cai-Cheng Technology Ltd, Dongjing Biotechnology Co, SGS Taiwan Limited, Taii Agricultural Co, Ltd, while iChase Co will showcase more cutting-edge technologies.
Many more products and technologies will be showcased in COA pavilion. Just click this link to see further exhibitors and products on show https://bit.ly/3CO7b82
Asia Agri-Tech Expo and Forum will be taken place from 10 to 12 of November 2022 at Taipei Nangang Exhibition Center, Hall 1.
See more details of the event here and special accommodation deal on this link.



